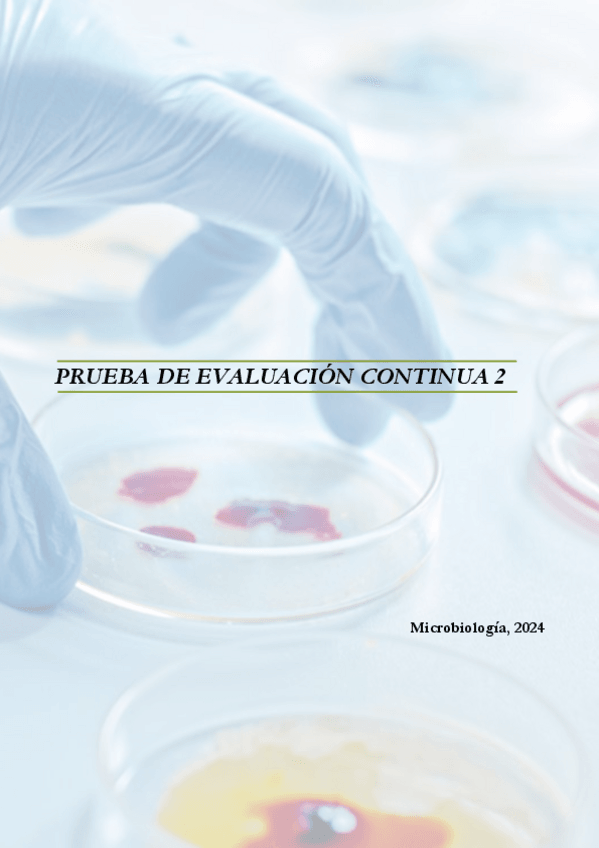

Microbiología Veterinaria
apuntes
-
Preguntas de Microbiología
Preguntas respondidas por temas de microbiología.
He publicado nuevos apuntes de 2º Microbiología Veterinaria: TODAS-LAS-PREGUNTAS.docx
Posibles preguntas de microbiología veterinaria del curso 2025/2026 completo
ejercicios
-
Preguntas microbiología veterinaria curso 2025/2026
Posibles preguntas de examen de microbiología veterinaria del curso 2025/2026
Preguntas del cuestionario online de evaluación continua 1
He publicado nuevos apuntes de 2º Microbiología Veterinaria: preguntas-microbiologia.pdf
He publicado nuevos apuntes de 2º Microbiología Veterinaria: PREGUNTAS-MICROBIOLOGIA-2024-2025-preparacion-examen.pdf
He publicado nuevos apuntes de 2º Microbiología Veterinaria: Preguntas-microbiologia-20242025.pdf
He publicado nuevos examenes de 2º Microbiología Veterinaria: Tema-6-micro.pdf
He publicado nuevos apuntes de 2º Microbiología Veterinaria: TEMA-20-23.-Preguntas-completo.pdf
He publicado nuevos apuntes de 2º Microbiología Veterinaria: TEMA-18-19.-Preguntas-completo.pdf
He publicado nuevos apuntes de 2º Microbiología Veterinaria: TEMA-17.-Preguntas-completo.pdf
He publicado nuevos apuntes de 2º Microbiología Veterinaria: TEMA-16.-Preguntas-completo.pdf
He publicado nuevos apuntes de 2º Microbiología Veterinaria: TEMA-14.-Preguntas-completo.pdf
He publicado nuevos apuntes de 2º Microbiología Veterinaria: TEMA-15.-Preguntas-completo.pdf
He publicado nuevos apuntes de 2º Microbiología Veterinaria: TEMA-13.-Preguntas-completo.pdf
He publicado nuevos apuntes de 2º Microbiología Veterinaria: TEMA-12.-Preguntas-completo.pdf
He publicado nuevos apuntes de 2º Microbiología Veterinaria: TEMA-11.-Preguntas-completo.pdf
He publicado nuevos apuntes de 2º Microbiología Veterinaria: TEMA-10.-Preguntas-completo.pdf
He publicado nuevos apuntes de 2º Microbiología Veterinaria: TEMA-9.-Preguntas-completo.pdf
He publicado nuevos apuntes de 2º Microbiología Veterinaria: TEMA-8.-Preguntas-completo.pdf
apuntes
-
Preguntas micro resueltas 2023-24 (T2-7)
He publicado nuevos apuntes de 2º Microbiología Veterinaria: Preguntas micro resueltas 2023-24 (T2-7)
He publicado nuevos apuntes de 2º Microbiología Veterinaria: RECOPILATORIO-PRUEBA-DE-EVALUACION-4-MICROBIOLOGIA.pdf
He publicado nuevos apuntes de 2º Microbiología Veterinaria: RECOPILATORIO-PRUEBA-DE-EVALUACION-3-MICROBIOLOGIA.pdf
He publicado nuevos examenes de 2º Microbiología Veterinaria: preguntas-tema-7-micro.pdf
He publicado nuevos examenes de 2º Microbiología Veterinaria: EXAMEN-PARCIAL-2-MICROBIOLOGIA-2024.pdf
He publicado nuevos examenes de 2º Microbiología Veterinaria: PRUEBA-DE-EVALUACION-CONTINUA-2.pdf
He publicado nuevos apuntes de 2º Microbiología Veterinaria: RECOPILATORIO-PRUEBA-DE-EVALUACION-2-MICROBIOLOGIA.pdf
He publicado nuevos apuntes de 2º Microbiología Veterinaria: tablas-micro-1.pdf
He publicado nuevos examenes de 2º Microbiología Veterinaria: Tema-8-microbiologia.pdf
He publicado nuevos examenes de 2º Microbiología Veterinaria: tema-4-micro.pdf
He publicado nuevos examenes de 2º Microbiología Veterinaria: Tema-3-microbiologia.pdf
He publicado nuevos examenes de 2º Microbiología Veterinaria: Tema-2-microbiologia.pdf
He publicado nuevos apuntes de 2º Microbiología Veterinaria: RECOPILATORIO-PRUEBA-DE-EVALUACION-1-MICROBIOLOGIA.pdf
apuntes
-
preguntas micro 22-23
He publicado nuevos apuntes de 2º Microbiología Veterinaria: preguntas micro 22-23
He publicado nuevos apuntes de 2º Microbiología Veterinaria: TEMA-20-23-MICROBIOLOXIA.pdf
He publicado nuevos apuntes de 2º Microbiología Veterinaria: TEMA-18-19-MICROBIOLOXIA.pdf
He publicado nuevos examenes de 2º Microbiología Veterinaria: Examen-micro-JULIO-2023.pdf
He publicado nuevos apuntes de 2º Microbiología Veterinaria: TEMA-16-MICROBIOLOXIA.pdf
He publicado nuevos apuntes de 2º Microbiología Veterinaria: TEMA-17-MICROBIOLOXIA.pdf
He publicado nuevos apuntes de 2º Microbiología Veterinaria: TEMA-15-MICROBIOLOXIA.pdf
He publicado nuevos apuntes de 2º Microbiología Veterinaria: TEMA-14-MICROBIOLOXIA.pdf
He publicado nuevos apuntes de 2º Microbiología Veterinaria: TEMA-12-MICROBIOLOXIA.pdf
He publicado nuevos apuntes de 2º Microbiología Veterinaria: TEMA-13-MICROBIOLOXIA.pdf
He publicado nuevos apuntes de 2º Microbiología Veterinaria: TEMA-11-MICROBIOLOXIA.pdf
He publicado nuevos apuntes de 2º Microbiología Veterinaria: TEMA-10-MICROBIOLOXIA.pdf
He publicado nuevos apuntes de 2º Microbiología Veterinaria: TEMA-8-MICROBIOLOXIA.pdf
He publicado nuevos apuntes de 2º Microbiología Veterinaria: TEMA-9-MICROBIOLOXIA.pdf